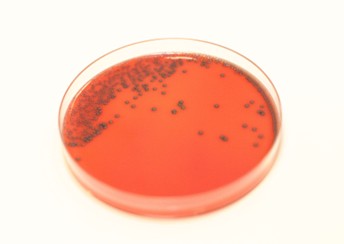
Gratis webinar om Listeria 16.desember kl. 09-10

av Wenche Brennbakk | jan 27, 2026 | Nyheter
Vi gjentar suksessen og arrangerer på nytt webinar med tema byggprøver, asbest og miljøkartlegging. Det er nå nye grenseverdier for asbest i luft og det er en innskjerping av regelverket. Våre fagfolk går bla. igjennom hvordan du kan gjennomføre riktig prøvetaking og...

av Wenche Brennbakk | jan 6, 2026 | Nyheter
Ønsker du mer kunnskap om hvordan håndtere utfordringer med Legionellabakterien? Meld deg på vårt digitale legionellakurs. Tema vil blant annet være prøvetaking og analysevurdering, forebygging og tiltak ved påvisning. Foredragsholdere er: – Lisbeth Blengsli...

av Wenche Brennbakk | des 11, 2025 | Ledig stilling, Nyheter
Vi søker nå en selvstendig, nøyaktig og engasjert analytiker/ingeniør til avd. Mat, Miljø og Veterinærmedisin ved vår lokasjon i Kristiansund. Stillingen er fast, 100 %, med oppstart 1.mars 2026. Søknadsfrist: 1.januar 2026. Arbeidsoppgaver er bla.: Utføre...

av Wenche Brennbakk | des 9, 2025 | Nyheter
16.desember kl.09:00-10:00 – Gratis webinar om Listeria Tema: Prøvetaking Listeria fra produkt og produksjonsmiljø For næringsmiddelprodusenter og kanskje spesielt innenfor sjømatnæringen, er det stort fokus på Listeria monocytogenes og analyser av både produkt...

av Wenche Brennbakk | nov 24, 2025 | Nyheter
Vi starter flytting av vårt laboratorium for organisk kjemisk analyse fra Kjelsåsveien til Philip Pedersens vei på Lysaker i uke 48. Deler av laboratoriet vil være operativt i Kjelsåsveien frem til jul. I flytteperioden kan leveringstid bli noe lenger enn normalt, men...

av Wenche Brennbakk | nov 14, 2025 | Blogg, Nyheter
Seniorrådgiver Karina Ødegård jobber med utslippsmålinger, luftkvalitet og spredningsberegninger her i Nemko Norlab. Hun er blant annet spesialist på diffuse utslipp. Karina er en klassisk fagnerd; lidenskapelig opptatt av bunnsolide datagrunnlag, nøyaktige målinger...